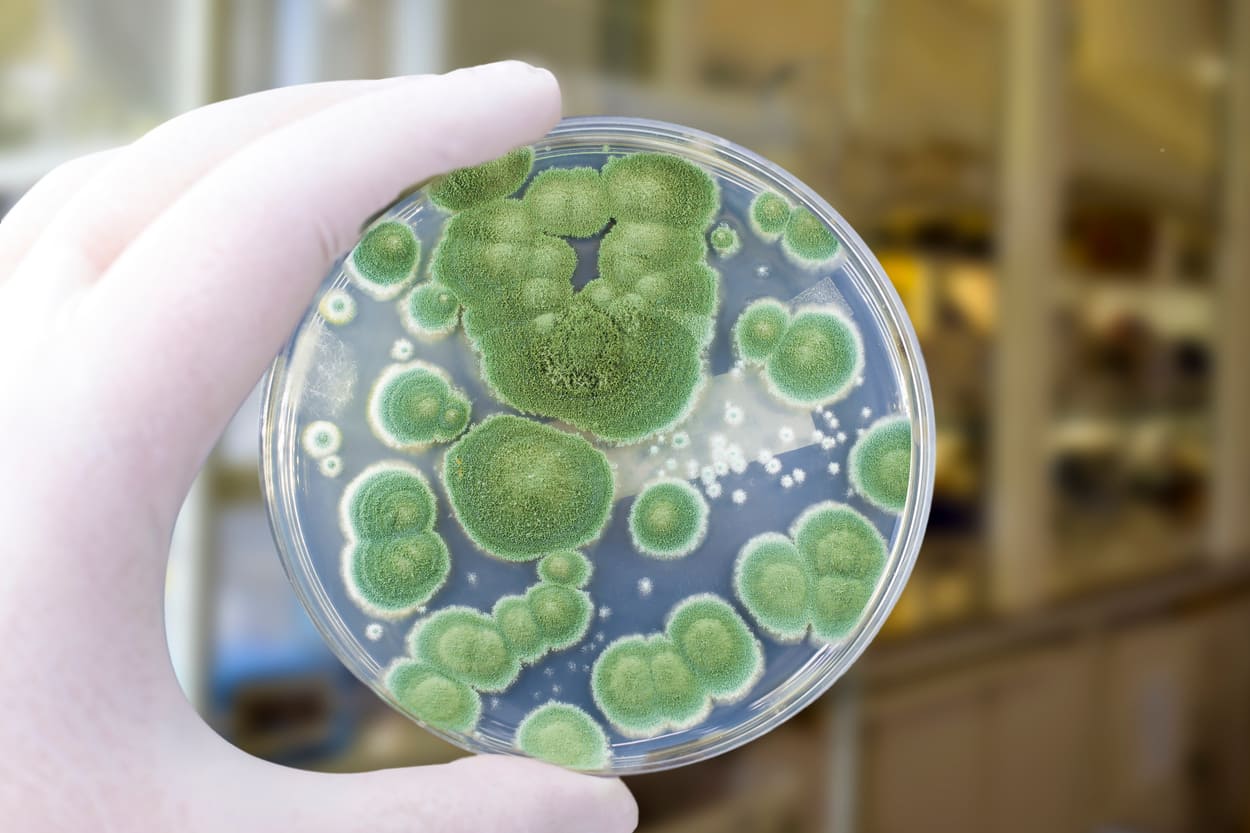

Top Things You Should Know About Mold in Commercial Buildings
Learn why mold is problematic in commercial buildings and how it impacts indoor air quality and occupant health.
Mold is a fungus that can grow virtually anywhere, both inside buildings and outdoors. Mold and mildew can be a concern for anyone, but they're particularly problematic for commercial building owners because they impact air quality and occupant health.
This article addresses the common mold problems in commercial buildings, how they impact indoor air quality, and what facility managers can do to help mitigate mold.
Mold And Indoor Air Quality
Unfortunately, any form of mold is quite dangerous and can make its way into any building.
Mold can be found in buildings on paper, textiles, and building materials. The worst place for mold to form is the HVAC ducts because air is circulated through there, and improper ventilation can cause moisture buildup. Which then can then distribute the mold throughout the entire HVAC system and building.
Mold significantly impacts the indoor air quality of any building. It is important to note that prolonged exposure to mold spores in buildings with poor indoor air quality can cause symptoms even if you're not sensitive to them and can cause a variety of health problems, such as:
- Headaches
- Breathing difficulties
- Skin irritation
- Allergic reactions
- Aggravation of asthma symptoms
In some cases, there is poor air quality and a mold problem by occupants complaining about the odor. Some compounds produced by molds are volatile and are released directly into the air. These are known as microbial volatile organic compounds (mVOCs). Because these compounds often have strong or unpleasant odors, they can be the source of odors associated with molds.
Exposure to mVOCs from molds has been linked to symptoms such as:
- Headaches
- Nasal irritation
- Dizziness
- Fatigue
- Nausea
Since mold exposure causes many health problems and structural damage to buildings, it is vital to notice signs of mold growth, mitigate them.
See the EPA's Building Air Quality: A Guide For Building Owners & Facility Manager - Appendix C: Moisture, Mold, and Mildew to read more.

Mold Growth In Commercial Buildings
Since mold requires water to grow, it is essential to prevent moisture problems in buildings. Moisture problems can have many causes, including uncontrolled humidity. Some moisture problems in buildings have been linked to changes in building construction practices during the 1970s, 80s, and 90s. These changes have resulted in tightly sealed buildings but may lack adequate ventilation, potentially leading to moisture buildup. Building materials, such as drywall may not allow moisture to escape easily.
Moisture problems may include:
- Roof leaks
- Landscaping or gutters that direct water into or under the building
- Unvented combustion appliances
- Delayed or insufficient maintenance is also associated with moisture problems in schools and large buildings.
Hidden Sources Of Mold
In some cases, indoor mold growth may not be apparent. Mold may be growing on hidden surfaces, such as:
- The backside of drywall
- Wallpaper
- Paneling
- The top of ceiling tiles
- The underside of carpets and pads
Possible locations of hidden mold can include:
- Pipe chases and utility tunnels (with leaking or condensing pipes)
- Walls behind furniture (where condensation forms)
- Condensate drain pans inside air handling units
- Porous thermal or acoustic liners inside ductwork
- Roof materials above ceiling tiles (due to roof leaks or insufficient insulation)
In some cases, building materials like drywall with vinyl wallpaper or wood paneling over it may create a vapor barrier and trap moister underneath their surface. Combining the two materials creates a moist environment where mold can grow.
If a building smells moldy or musty, you may suspect hidden mold, but you cannot find the source of the moister, or there is water damage, and the occupants of the building are also reporting health problems.
Five Most Dangerous Mold Species
Many different types of mold exist, and exposure to all of them over time are irritants. But the five most dangerous mold species to look out for are Alternia, Aspergillus, Cladosporium, Penicillium, and Stachybotrys. Below you will find a summary of each species.
Alternia
70% of those with mold allergies react to Alternia. This mold is at its highest concentration during the summer, when the wind carries spores indoors, and is powdery and olive-green to black.
Aspergillus
The second most common mold to infect humans, many commercial buildings are found to contain Aspergillus, whose spores are found in higher concentrations indoors than out. Yellow-green with a reddish-brown underside, it's a toxic mold capable of producing mycotoxins and is known to cause serious health issues in humans and animals.
Cladosporium
Cladosporium comes in many colors (olive-green, brown, grey, black) and grows at nearly any temperature – even in cold storage. It's known as a significant trigger for asthma attacks.
Penicillium
It is named after the Latin word for 'paintbrush' due to its ability to produce enormous quantities of greenish, bluish, or yellowish spores. Though generally toxic to humans, it can be beneficial in antibiotics if carefully cultured.
Stachybotrys
Dark brown or black in color, Stachybotrys, or 'black mold' is slow to develop but can overtake other types of molds that colonize before it. It is commonly found on cellulose (plant-based) materials like paper, wood, and cotton and is highly toxic and a known respiratory irritant.
10 Ways to Prevent Mold Growth in Commercial Buildings
The key to mold control is moisture control. Solve moisture problems before they become mold problems:
EPA's Mold Prevention Tips
- Fix leaky plumbing and leaks in the building envelope as soon as possible.
- Watch for condensation and wet spots. Fix source(s) of moisture problem(s) as soon as possible.
- Prevent moisture due to condensation by increasing surface temperature or reducing the moisture level in the air (humidity). To increase surface temperature, insulate or increase air circulation. To reduce the moisture level in air, repair leaks, increase ventilation (if outside air is cold and dry), or dehumidify (if outdoor air is warm and humid).
- Keep heating, ventilation, and air conditioning (HVAC) drip pans clean, flowing properly, and unobstructed.
- Vent moisture-generating appliances, such as dryers, to the outside where possible.
- Maintain low indoor humidity, below 60% relative humidity (RH), ideally 30-50%, if possible.
- Perform regular building/HVAC inspections and maintenance as scheduled.
- Clean and dry wet or damp spots within 48 hours.
- Don't let foundations stay wet.
- Provide drainage and slope the ground away from the foundation.

Managing Mold In Commercial Buildings
Mold growth does not require the presence of standing water; it can occur when the high relative humidity of building surfaces allows sufficient moisture to accumulate. Meaning mold growth can happen anywhere, even under the most managed conditions.
In addition to the prevention tips above and mediating mold when identified, businesses, schools, and organizations need to focus on indoor air quality measures that will help capture airborne mold spores. Implementing building-wide HVAC induct with air purification featuring ActivePure® Technology or UV-C Disinfection can help remove mold spores in the air and on surfaces. However, dead mold spores can still produce allergic reactions. So implementing in-room portable air purification systems like the Beyond Guardian Air can help capture dead or alive mold spores. The Beyond Guardian also features ActivePure® Technology, which is proven to remove mold.



.png)
















